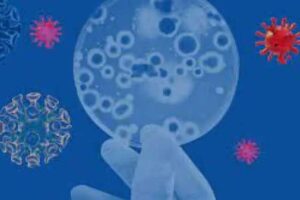

கொரோனா வைரசின் புதிய உருமாற்றமான ஒமைக்ரான் வைரஸ் தோலில் 21 மணி நேரமும், பிளாஸ்டிக் பரப்புகளில் 8 நாட்களுக்கு மேல் உயிர்வாழும் என்று ஆய்வில் தெரியவந்துள்ளது.
கொரோனா வைரசின் புதிய உருமாற்றமான ஒமைக்ரான் வைரஸ் தோலில் 21 மணி நேரமும், பிளாஸ்டிக் பரப்புகளில் 8 நாட்களுக்கு மேல் உயிர்வாழும் என்று ஆய்வில் தெரியவந்துள்ளது.
இதுதொடர்பாக ஜப்பானில் உள்ள கியோட்டா மாகாண மருத்துவ பல்கலைக்கழகம் நடத்திய ஆய்வில் இருந்து இந்த விடயம் கண்டறியப்பட்டுள்ளது. இந்த ஆய்வின்போது, சீனாவின் உகானில் உருவான கொரோனா தொடங்கி பல்வேறு மாறுபாடுகள் வரையில், சுற்றுச்சூழல்தன்மையின் வேறுபாடுகளை இவர்கள் ஆராய்ந்து உள்ளனர்.
இதில் ஒமைக்ரான் வைரஸ் தோலில் 21 மணி நேரத்துக்கு மேலாக உயிருடன் இருக்கும், பிளாஸ்டிக் பரப்புகளில் 8 நாட்களுக்கு மேல் உயிர்வாழும் என்ற தெரியவந்துள்ளது. கவலைக்குரிய மாறுபாடுகளாக அடையாளம் காணப்பட்டுள்ள உருமாறிய கொரோனா வைரஸ்கள், சுற்றுச்சூழல் ஸ்திரத்தன்மை தொடர்பு பரிமாற்றத்தின் அபாயத்தை அதிகரிக்கும் மற்றும் அவற்றின் பரவலுக்கு பங்கு அளிக்கும் என்று ஆராய்ச்சியாளர்கள் கூறுகின்றனர்.
கொரோனா வைரஸ் பிளாஸ்டிக் பரப்பின் மீது 56, ஆல்பா 191.3, காமா 59.3, பீட்டா 156.6, டெல்டா 114 மணி நேரம் வாழும், ஒமைக்ரான் 191.3 மணி நேரம் வாழும். ஒமைக்ரான் தோலில் 21 மணி நேரத்துக்கு மேலாக உயிர்வாழ்கிறபோது, ஆல்பா 19.6, பீட்டா 19.1, காமா 11, டெல்டா 16.8 மணி நேரம் உயிர்வாழும் என்று தெரிவிக்கப்பட்டுள்ளது.
மேலும் உலக சுகாதார நிறுவனத்தால் முன்மொழியப்பட்டபடி, தற்போதைய தொற்று கட்டுப்பாடு (அடிக்கடி கை கழுவுதல்) நடைமுறைகளுக்கு, கிருமிநாசினிகளை (Hand sanitizer) பயன்படுத்த பரிந்துரைக்கப்படுகிறது என்று ஆராய்ச்சியாளர்கள் தெரிவித்துள்ளனர்.















